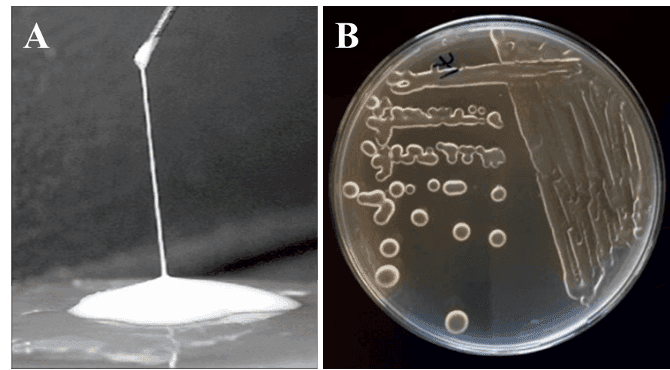
Soutenance de Thèse de Doctorat en Molécule Bioactives, Santé et Biotechnologies et Ingénierie Tissulaire par Madame Sihame AKHTACH

CEDOC
Soutenance de Thèse de Doctorat en Molécule Bioactives, Santé et Biotechnologies et Ingénierie Tissulaire par Madame Sihame AKHTACH
Sous le Titre : Exopolysaccharides of lactic acid bacteria: production, characterization, and elaboration of multifunctional composite nanofibres for biomedical application
Cette thèse est Co-encadrée par le Professeur Khalil EL Mabrouk de l’équipe Matériaux, Biomatériaux et Ingénierie Tissulaire de l’Université Euromed De Fès et Professeur Rajae Belkhou du Laboratoire de Molécules Bioactives, santé et biotechnologies de l’FST de Fès.